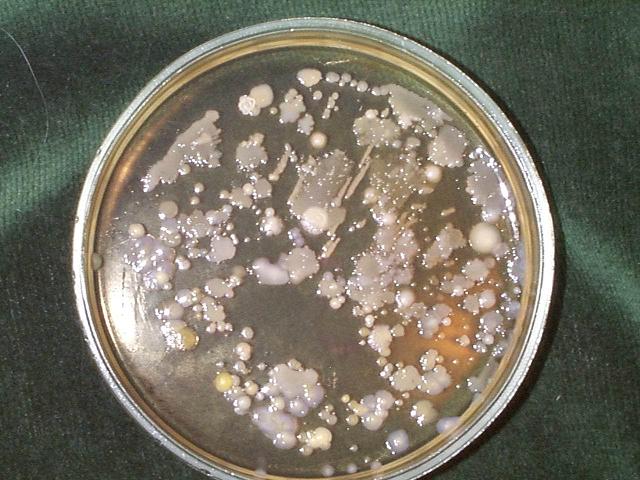

Рубрика: Эстетическая медицина
Доктор биологических наук
|
Современные представления о составе микробиоты
кишечника по данным молекулярных исследований |
|
Специфика
микрофлоры половых органов мужчин в норме, при простатите и мужском бесплодии |
На сегодня нет точного описания архитектуры
микробного сообщества пристеночного слоя кишечника. Попытаемся предложить
модель биопленки на основе известных фактов. Микроорганизмы, в количестве 1011
клеток/см3 должны быть распределены в пристеночном слое муцина –
относительно прочного геля, состоящего из пептидогликана, продуцируемого
бокаловидными клетками эпителия кишечной слизистой оболочки. Сразу следует
заметить, что он близок по химической природе полисахаридной защитной капсуле,
которой окружают себя многие микробы. Т.е. в муцине они должны себя
«чувствовать» как рыба в воде. Такая среда выглядит пригодной для существования
микроорганизмов в тонких слоях муциновой слизи в виде равномерно распределенных
клеток на достаточно близком расстоянии (порядка размера микробной клетки) друг
от друга. Такое расположение должно обеспечивать контакт с диффундирующим в
муцин химусом и клетками между собой для быстрого обмена продуктами
метаболизма. Оно должно отвечать представлению о биопленке, как о
псевдоцитологической структуре (Фото 1.)

Фото 1. Скопления бактерий, колонизирующих муцин толстого кишечника
(заимствовано с сайта
В достаточно толстом слое муцинового геля можно предполагать и видеть другие формы микробной биопленки – в виде слоя, прикрепленного к клеткам эпителия, или отдельно расположенных конгломератов клеток (фото 2).

Фото 2. Микроколонии бактерий в биоптате прямой кишки расположены вокруг
эпителиальных клеток или в виде отдельных
агрегатов
(заимствовано с сайта
Достойна удивления способность микробиоты кишечника сохранять стабильность в условиях разнородных химических и корпускулярных потоков, пронизывающих муцин вдоль и поперек. В соответствии с физиологическими канонами через кишечную стенку и вдоль нее ежесуточно проходит десять литров жидкости, включая слюну, желудочный сок с пищевым химусом, желчные и печеночные секреты и прочее. В противоположном всасыванию направлении движется муцин, который микробы кишечной стенки должны успевать переваривать на мономерные составляющие со скоростью его образования клетками слизистой оболочки.

Фото 3.
Выявление кишечных бактерий отдельных родов в искусственной среде,
моделирующей кишечную микробиоту. Применен метод FISH (Fluorescent In Situ Hybridization) – гибридизация тестовой ДНК непосредственно в
пробе с окрашиванием различными флюоресцентными метками
(заимствовано с сайта
Специальные исследования показали, что в биопленке по иному, в сравнении с чистыми культурами
бактерий, происходят их многочисленные физиологические процессы, в том числе
продукция метаболитов и биологически активных веществ. Сообщество организует
единую генетическую систему в виде плазмид – кольцевых ДНК, несущих
поведенческий код для членов биопленки, определяющих их пищевые (трфические),
энергетические и другие связи между собой и внешним миром. Последнее получило
специальное определение как социальное поведение (quorum sensing) микроорганизмов. Реакция микроорганизмов на изменение условий
окружающей среды в биопленке существенно отличается от реакции каждого
отдельного вида в монокультуре. Такая организация обеспечивает ее физиологическую
и функциональную стабильность и, следовательно, является залогом конкурентного
выживания в экологической нише. В организме человека специфическое преимущество
такой организации заключается в обеспечении гомеостаза органов, функциональность
которых зависит от населяющих их микробов.
Здоровый вид кожи, нормальное пищеварение,
устойчивость к внешней инфекции (состояние иммунитета) человека во многом
определяется стабильностью, можно сказать, «здоровьем» его микрофлоры.
Преимущество коллективного реагирования
имеет и отрицательную сторону: таким сообществом трудно управлять извне.
Например – лечить заболевания полимикробного происхождения, когда
чувствительность к антибиотикам микроорганизмов, ассоциированных в биопленку, не
соответствует таковой, определенной в лабораторных тестах на клинических
изолятах чистых культур бактерий. Коллективный иммунитет биопленки практически
сводит на нет хорошую идею коррекцию дисбактериозов с помощью пробиотиков –
препаратов живых культур ключевых микроорганизмов кишечника – бифидобактерий,
лактобацилл, энтеробактерий и других. Несомненно, они создают эффект, но не
всегда и не такой, как предполагалось по идее. Это происходит из-за
коллективного иммунитета микробиоты (организованной микрофлоры) кишечника.
Микробы, выращенные искусственно, являются инородными, как инородны
пересаживаемые человеку органы и ткани других людей – доноров, или животных.
Они отторгаются вследствие биологической несовместимости. Биотехнологические
пробиотики не имеют «пароля» для входа микробов внутрь биопленки кишечника, и
поэтому пребывают в нем транзиторно, как микрофлора пищи. Это признают фирмы –
производители пробиотиков и не утверждают, что их добавки восполняют физически
дефицит соответствующих содержимому пробиотика микроорганизмов, но стимулируют
рост ущемленной популяции. Отсутствие приживаемости чужеродных микробов
подобного вида есть косвенное доказательство существования микрофлоры человека
как самостоятельного органа. Появился термин «парацитология биопленки», как
структуры, похожей на ткань высших организмов что подразумевает выполнение в
ней законов, ей присущих.
Существует еще множество обстоятельств, в силу которых микробиоту человека следует рассматривать как индивидуально
специфичную, генетически детерминированную и, видимо, – наследуемую. Они
подробно рассмотрены в трехтомнике проф. Б.А.Шендерова «Медицинская микробная
экология и рациональное питание». На основании такого вывода Б.А.Шендеровым
предложена (в виде авторского свидетельства, полученного в начале девяностых
годов прошлого века) идея консервации индивидуальной микрофлоры в молодом
здоровом периоде жизни конкретного человека с целью допирования ее в будущем
при серьезных нарушениях кишечного биоза с целью его оздоровления, даже можно
сказать - омоложения. Гастроэнтерологам же известны случаи «пересадки»
микрофлоры больному от родственника «пер клизмум» с положительным эффектом
коррекции дисбактериоза кишечника.
Сведения о природе микробиоценоза кишечника, накопленные к настоящему
времени, выглядят достаточными для
понимания его функционирования, как физиологически активного органа человека.
Однако для их реализации в управлении этим органом при патологиях,
причинно-следственным образом связанных с дисбактериозом, недостает
количественного метода определения изменений в составе достаточно широкого
круга ключевых микроорганизмов и их мониторинга в процессе коррекции. Причем
желательно анализировать состав пристеночной кишечной микробиоты, а не
микрофлоры фекалий, как это принято повсеместно. Именно в мукозном слое,
облегающем слизистую оболочку кишечника происходит усвоение пищевого химуса,
поступающего из желудка, усвоение необходимых питательных веществ
клетками эпителия кишечной стенки и дополнительная продукция
микроорганизмами большого числа биологически активных веществ: ферментов,
витаминов, антибиотиков, иммуностимуляторов, а также токсинов и метаболитов,
вредных для человека. Предполагается, что отсутствие баланса в их продукции
связано с патологическими проявлениями самого разного характера: кишечные
расстройства, кожные заболевания, половые дисфункции и сердечная
недостаточность. Микрофлора фекалий является отходом этих процессов, в котором
продолжается продукция микроорганизмов, но уже в иных условиях по сравнению с
верхними отделами кишечника. По мнению известного специалиста в области
клинической микробиологии проф. А.Н.Маянского она отражает скорее полостную
(свободноживущую, или планктонную), чем пристеночную биопленку, которая более
стабильна и физиологична. Цитируя Маянского в части определения дисбактериоза
кишечника по фекалиям нельзя не согласиться, что «Фактически это дорогостоящее
(тем более, что тестирование рекомендуется делать в динамике), трудоемкое
исследование с невысокой (если не с
нулевой) отдачей».
Подходящий для решения такой задачи метод появился в России в начале 90-х
прошлого уже века. Он был разработан на базе исследований НИИ биологического
приборостроения при поддержке академика РАН Г.А.Заварзина и гранта Министерства
экологии и охраны недр РФ «Экологическая безопасность России». Метод основан на выявлении присутствия
микроорганизмов в объектах окружающей среды (воде, почве, стоках и т.п.) по
специфическим для них химическим веществам – маркерам из числа жирных кислот,
альдегидов и стеринов, входящих в состав их клеточной стенки. Специфичность
означает, что подобные вещества содержатся только в липидах микроорганизмов и
не содержатся в среде их обитания. Поэтому, имея достаточно чувствительный
метод анализа их можно обнаружить и измерить количественно непосредственно в
среде обитания, избежав необходимости предварительно культивировать их на
искусственных средах. Это оказалось возможным сделать с помощью метода газовой
хроматографии в сочетании с масс-спектрометрией (сокращенно – ГХ-МС). Существо анализа
состоит в прямом извлечении с помощью химической процедуры высших жирных кислот
из образца, подлежащего исследованию (почвы, ила, клинического материала), их
разделения на хроматографе в капиллярной колонке высокого разрешения и анализа
состава в динамическом режиме на масс-спектрометре. Поскольку хроматограф
соединен в едином приборе с масс-спектрометром и снабжен компьютером с
соответствующими программами автоматического анализа и обработки данных, сам
процесс анализа занимает 40 мин. Его результатом является определение состава
микробных маркеров с точностью 2% относительных. Вместе с пробоподготовкой и
расчетом состава микробного сообщества по отдельной программе стандартная
процедура контроля 170 микроорганизмов в
пробе занимает около 5 часов.
Метод детектирования
микроорганизмов по ЖК-маркерам сродни генетическому (ПЦР, определение
последовательности нуклеотидов 16sРНК и
пр.), поскольку состав жирных кислот детерминирован в ДНК и воспроизводится
путем репликации участка генома транспортными РНК и последующего синтеза ЖК в митохондриях по матричным РНК.
Поэтому профиль ЖК бактерий является их визитной карточкой или фингерпринтом
как отпечатки пальцев людей (Митрука, 1978). Он так же консервативен, как
строение ДНК, но и так же подвержен мутациям под действием факторов окружающей
среды. Стабильность набора жирных кислот, составляющих клетки микробов,
подтверждается исследованиями в области бактериальной палеонтологии, которые
показывают, что до глубины времен в 2,5 млрд лет состав ЖК отдельных микробов и пула их жирных кислот в целом
остается постоянным (Шеховцова, 2002). Бактерии,
законсервированные в донных отложениях древних озер Антарктиды (возраст 1,5 миллиона
лет), удается оживить в лабораторных исследованиях и показать их идентичность
современным видам по молекулярным признакам – составу жирных кислот клеточных
стенок (Воробьева, 2002).
По этому принципу построена
хемодифференциация микроорганизмов, которая широко используется как метод их
идентификации и подтверждения таксономического положения (Minnikin, 1985). Он применяется для работы с монокультурами
микроорганизмов и основан на использовании очень больших баз данных, содержащих
сведения о составе жирных кислот нескольких тысяч штаммов бактерий и
микроскопических грибов. Примером такой системы является специализированный
хроматограф Microbial Identification System, выпускаемый фирмой MIDI Inc.,
Делавер, США [Stead, 1992]. Особенности состава жирных кислот теперь
используют наряду с другими параметрами в бактериальной таксономии и
клинической бактериальной диагностике [Вейант, 1999 ].
Методология анализа микробных сообществ методом ГХ-МС была опубликована как
в отчете по теме гранта Минэклогии РФ «Экологическая безопасность России», так
и в последовавшем описании патента на способ анализа. Она распространена при
поддержке академиков РАМН Ю.Ф. Исакова и А.А.Ворбьева и проф. Н.В.Белобородовой
на диагностику воспалительных процессов и дисбиозов в клинической практике.
Суммарно метод в приложении к экологическим, биотехнологическим и клиническим
проблемам изложен в докторской диссертации Г.А. Осипова (1996), пяти кандидатских диссертациях, статьях в
отечественной и зарубежной периодике, пособиях для врачей. Часть материала
представлена в Интернет на сайте Русского медицинского сервера www.rusmedserv.com/microbdiag на русском и www.rusmedserv.com/microbdiag/eng на
английском языках.
В основе метода микробной диагностики лежат
многочисленные исследования последних двадцати лет отечественных и зарубежных
ученых в области жирнокислотного состава микробной клетки и хемодифференциации
микроорганизмов. Это труды C.W. Moss, E.Jantzen, D.B. Drucker, C.Asselineau,
M.Goodfellow, D.E.Minnikin за рубежом З.П.Васюренко, Л.В.Андреева, В.И.Седова,
С.Г.Батракова, Б.В.Розынова, Е.А.Киприановой
и других в России и бывшем СССР.
Он развивался параллельно с исследованием
экологических микробных сообществ по принципу
специфики PLFA – фосфолипидных жирных кислот, корифеем в области
которого является американский ученый из Университета штата Теннеси (Ноксвилл)
D.C.White (milipids@aol.com) и его последователи D.Ringelberg, P.D.Nichols. Однако в
отличие от российских им не удалось разработать методику масштабного
количественного видового анализа микробных сообществ в экологии и медицине по
микробным маркерам и суммарным профилям жирных кислот.
Наболее близко к диагностике инфекционных
заболеваний по маркерам подошел шведский ученый Lennart Larsson из Унивеситета
Лунда (lennart.larsson@mmb.lu.se), с которым мы в настоящее
время сотрудничаем.
Итак, вернемся к кишечнику, то есть к населяющим
его микроорганизмам. По современным представлениям они являются основными
переработчиками потребляемой человеком пищи в молекулярную форму. Только в
таком виде она может быть доставлена посредством всасывания на кишечной стенке
в кровь и далее в клетки тела. Кроме того, микробы синтезируют в своих клетках
множество необходимых человеку веществ – витаминов, ферментов, незаменимых
аминокислот и других. От стабильности этого процесса и зависит здоровье,
следовательно - тонус и качество жизни человека. Как отмечалось, для контроля и управления микробиотой кишечника
необходим количественный метод анализа ее состава, и он получен в виде
опосредованного определения ее состава по данным масс-спектрометрии жирных
кислот. При использовании этого метода накоплена информация по пристеночной микрофлоре
тощей, подвздошной и ободочной кишок путем ГХ-МС анализа микробных маркеров
в биоптатах, получаемых в отделениии
патологии тонкого кишечника ЦНИИГ, возглавляемом профессором Пафеновым А.И.,
при исследованиях здоровых добровольцев и больных с синдромом раздраженного
кишечника и антибиотико-ассоциированной диареей. Эти исследования впервые
позволили установить характер распределения микроорганизмов по отделам
кишечника. Их сопоставление с анализом фекалий у тех же пациентов показали, что
адекватно динамике заболевания и лечения пробиотиками меняется только
пристеночная микробиота. Микрофлора фекалий каких-либо корреляций с процессом
не обнаруживает.
Нам удалось измерить
концентрацию микробных компонентов непосредственно в месте обитания, где
присутствуют сами клетки микробов кишечной стенки. Поэтому мы вправе делать
прямые доступные нам сопоставления между концентрацией маркеров и числом
микробных клеток в условиях отсутствия пищевой липидной компоненты, поскольку
биоптаты получали натощак. Такая логика убеждает нас в том, что мы
измерили ведущую микрофлору кишечной
стенки. Ведущую в количественном отношении, так как оказалось, что при наличии
биоптата весом 4мг мы можем детектировать микроорганизмы начиная с концентрации
104 - 105 кл/г, поэтому, значительная часть
микрофлоры осталась вне поля наших возможностей. Как оказалось, общая
численность микроорганизмов кишечной стенки в норме имеет величину в пределах
(0,5-1,3)х1011 кл/г в зависимости от отдела кишечника.
Плотность заселения стенки
кишечника в дистальном направлении
меняется мало: в подвздошной кишке она в два раза меньше, а в толстой в
полтора раза больше, чем в тощей. Измеренная нами пристеночная микрофлора
оказалась существенно более концентрированной, чем просветная (по литературным
данным [Schaechter, 1993]), которая в тонкой
кишке на шесть а в подвздошной кишке на пять порядков ниже по численности (до 105
– 106 кл/мл соответственно), и только в ободочной кишке соответствует
таковой в ее содержимом. Видовой состав
микроорганизмов соответствует известным представлениям о компонентах
кишечной микрофлоры, в особенности – микроорганизмов фекалий [24]. Однако
сходство ограничивается категориями общего характера: качественного состава и
приоритетного (рангового) содержания основных элементов кишечного
микробиоценоза. Действительно, в толстом кишечнике и фекалиях существенно
больше анаэробов.
Полученная нами общая
численность микроорганизмов для фекалий находится в пределах интервала значений
0,6-5´ 1011 кл/г, что
согласуется с известными литературными данными измерений генетическим и культурально-биохимическим методами. Совпадает с известными
оценками и относительное количество анаэробов в них, которое по нашим данным
составляет 88%. Родовое распределение трудно сравнивать с литературными данными,
так как в них приводится очень широкий диапазон значений, - в пределах 3-6 порядков.
Тем не менее, совпадает наша оценка о приоритете рода Eubacterium, численность которых имеет порядок 1011 кл/г (109 – 1012
по литературным данным), о количестве
бактероидов 1010 кл/г (1010 - 1012 по
известным данным), клостридий - 6 х 1010 кл/г (105 - 1011
соответственно), бифидобактерий 1010 кл/г (1010 -
1012), а также по энтерококкам, энтеробактериям, лактобациллам и стафилококкам. Этот результат позволяет
утверждать что анализ микробиоты фекалий методом ГХ-МС по жирным кислотам
клеточной стенки микрорганизмов дает достоверные данные об их численности.
Следовательно, можно считать так же достоверными приводимые здесь сведения о
составе микроорганизмов в биоптатах кишечной стенки.
Результаты разных исследований микробиоты фекалий отводят бифидобактериям в их составе почти от 100% до 0,1% (табл. 1). Диапазон в три порядка вряд ли вызван тем, что люди разные, - в каждом исследовании приводится серьезная статистика и добросовестная аналитическая процедура. Разницу следует, скорее, отнести к особенностям сопоставляемых методов количественных измерений. Не вдаваясь в детали, можно заключить, что эффект доминирования бифидобактерий создает рутинная практика анализа только бифидобактерий и условно-патогенной микрофлоры при исследованиях дисбактериозов. Как видно из поля зрения микробиолога при этом выпадают эубактерии, бактероиды и клостридии, которых в фекалиях по современным оценкам по крайней мере в несколько раз больше, чем бифидобактерий. Это заблуждение выглядит естественным, если вспомнить, что в рамках общей микробиологии принято считать, что в микробном сообществе в среднем культивируемыми являются не более 20% микроорганизмов любого местообитания. Что касается фекалий, то по оценкам молекулярно-генетическими методами так же оказывается, что определение 60-80% их микробиоценоза не доступно для культуральных методов. Данные масс-спектрометрии коррелируют с генетическими (в рамках сопоставимости микробиологических количественных измерений) и одинаково показывают, что эубактерий, бактероидов и клостридий вместе и по отдельности на порядок больше, чем бифидобактерий.
Применение масс-спектрометрического метода дало возможность измерить
численность более 50 таксонов микроорганизмов кишечника не только в фекалиях,
но и в отделах самого кишечника, путем анализа их маркеров (жирных кислот)
непосредственно в биоптатах, полученных при интестиноскопии
и колоноскопии с ретроградной илеоскопией. Эти данные показывают, что там также
доминируют эубактерии, а их видовой состав существенно меняется по длине
кишечника. Следует отметить филогенетическое родство эубактерий и клостридий.
В определителе Берджи 9-го издания прямо сказано, что род Eubacterium создан для удобства, чтобы поместить в него слабо спорообразующие клостридии.
Таким образом, кишечная микробиота представляет собой доминирующий
континуум штаммов и видов родов Clostridium и Eubacterium при равновеликом суммарном количестве
бактероидов, бифидобактерий и лактобацилл.
Приведенные данные свидетельствуют о важности рода Eubacterium в формировании и функционировании кишечной микробиоты. Теперь уже трудно,
после проведенного анализа филогенетических связей, оторвать его от рода Clostridium (по крайней
мере группы C.coccoides) и рассматривать их как пищеварительно важную
группу пептолитических и целлюлолитических организмов. Следует отметить
принципиально важную особенность
представителей рода Eubacterium, заключающуюся в способности образовывать
водород. Это ключевое свойство консорциумов микроорганизмов, осуществляющих
дайджест органического субстрата при анаэробных процессах в природе (болота), в
рубце жвачных и в биотехнологии при анаэробном сбраживании разного рода отходов
и получении биогаза. Мукозный слой кишечника человека по существу является
аналогичным биореактором. Там идет образование метана, следовательно, работают
архебактерии-метаногены, эффективность которых строго зависима от концентрации
водорода в системе. В метаногенном сообществе водородные бактерии играют
ключевую регуляторную роль еще и благодаря обратной связи процесса продукции и
потребления водорода на первичный процесс расщепления углеводов с образованием
ацетата. При СРК, как следует из наших измерений, наибольшие изменения
претерпевает численность эубактерий, что должно приводить к увеличению концентрации
водорода в системе. Действительно, ранее экспериментально показано четырехкратное
увеличение концентрации водорода в выдыхаемом воздухе у больных с СРК (King, 1998) и его
возвращение в норму при снятии симптомов
в результате ограничительной диеты.
Основную долю (от 70% в
тощей кишке до 90 в фекалиях) микроорганизмов во всех отделах кишечника составляют анаэробы. Второе место по численности в тощей кишке занимают
аэробные актиномицеты – 17% (в фекалиях
их всего 0,7 %). Аэробные кокки (стафилококки, стрептококки, энтерококки) и
коринеформные бактерии) – составляют 5% колонизации тонкого кишечника по
сравнению с 0,7 % в фекалиях. Доля энтеробактерий и энтерококков по отделам
кишечника и в фекалиях близка к 2%.
Неожиданным
результатом, несомненно, является обнаружение значительного количества аэробных
актиномицетов. Специфичность их маркеров - разветвленных жирных кислот с
метильной группой в положении Δ10 не позволяет предполагать какие-либо
иные таксономические группы микроорганизмов, кроме представителей порядка Actinomycetales, содержащих в
составе клеточной стенки миколовые кислоты, являющиеся источником
10Ме-разветвленных ЖК. Они содержаться в микобактериях, нокардиях, родокках, видах
Actinomadura и других
актиномицетах, но не найдены у высших организмов (грибов, растений, животных).
Присутствие этих молекул в биоптатах кишечника, крови и других органах и
жидкостях человека подтверждается масс-спектрами, а также их анализом в составе
музейных культур соответствующих микроорганизмов. Бактерии родов Streptomyces и Nocardiopsis подтверждены
также уникальным маркером изо-гексадекановой кислотой (i16). Кроме того, Nocardiopsis dassonvilley выделен нами в чистой культуре из
кишечника.

Фото 4. Колония аэробного актиномицета Nocardiopsis dassonvilley, выделенного из пристеночного слоя тонкого кишечника.
К ним следует добавить микроорганизмы: Propionibacterium, Actinomyces, Brevibacterium, которые также выделены в чистой культуре и коринеформные бактерии. Наконец, если учесть, что до настоящего времени в некоторых руководствах по микробиологии, как и ранее [Bergi, 8-th Ed.], род Bifidobacterium относят к семейству Actinomycetaceae, то окажется, что актиномицеты филогенетически близки традиционно известным представителям пристеночной микробиоты кишечника. Они повышают значимость микробиоты кишечника для организма хозяина, так как актиномицеты превосходят все прочие микроорганизмы по продукции антибиотиков и витаминов и обладают мощным ферментативным аппаратом. Высокая степень колонизации кишечника актиномицетами не выглядит необычным явлением, если иметь в виду, что они широко распространены в окружающей среде – почве, воде, воздухе, на внутренних стенах жилых и производственных помещений [Andersen, 1998]. Их обитание в организме человека при таких обстоятельствах выглядит естественным. Действительно, в руководствах по клинической микробиологии отмечается обнаружение актиномицетов и родственных организмов, таких как Mycobacterium, Actinomadura, Propionibacterium, Actinomyces, Corynebacterium, Bifidobacterium в кишечнике и других органах человека. Там они фигурируют (в том числе и бифидобактерии) как участники инфекционных и воспалительных процессов (Mannual on Clinical Microbiology). Однако патогенность актиномицетов, чувствительность к антибиотикам, способы лечения связанных с ними заболеваний являются предметом единичных специализированных лабораторий и клиник в мире. Трудности в их бактериальной диагностике и культивировании послужили препятствием широкой известности этих микроорганизмов в клинической практике. В том числе при многочисленных заболеваниях, связанных с изменением микробиоты кишечника и кожи.
Фото 5. Обильный рост на чашке Петри бактерий из биоптата стенки тонкого кишечника свидетельствует о многочисленности и многообразии микробного сообщества.

Фото 6. Микроскопический гриб из пристеночного слоя тонкого кишечника
Существенный вывод для практики диагностики и мониторинга
пристеночной микробиоты кишечника дало
одновременное определение концентрации микробных маркеров в крови тех же
пациентов. Оказалось, что их
концентрация коррелирует с концентрацией микробов на кишечной стенке,
измеренной в биоптатах. Это физиологически закономерно, так как при
естественной гибели микробных клеток их липиды разбираются ферментной системой
кишечника, при этом не использованные на его стенке жирные кислоты
микроорганизмов поступают в кроветок.
Это явление дает возможность
контролировать состояние микробиоты кишечника по данным анализа микробных
жирных кислот в капле крови (40 мкл) из
пальца.
Следует лишь учесть, что в
кровь попадают также микробные молекулы от микроорганизмов, обитающих на других
слизистых оболочках человека (ротоглотка, урогенитальный тракт), а также из
очагов воспаления, вызванных индигенной (собственной) микрофлорой или
возбудилем, поступившим извне. Наличие
маркеров микроорганизмов такого происхождения в крови теоретически обусловлено механизмом иммунного ответа на
появление возбудителя. Фагоцитирующие клетки организма человека адсорбируют и
переваривают антигены микроорганизмов, в
том числе и целые клетки, и выводят продукты лизиса в поток лимфатической и
кровеносной систем. Кроме фагоцитоза, клетки микроорганизмов разрушаются под
действием других механизмов, в том числе собственного апоптоза и лизиса ферментами
белкового комплемента крови и других компонентов иммунной защиты. В любом
случае разрушение происходит в конечном счете до мономерных составляющих биополимеров.
Исходя из основ физиологии обмена биологических жидкостей человека [Физиология
человека, М. Мир, 1996], обмен 70% жидкости плазмы с интерстиционным
пространством происходит за 1 мин. Поэтому малые фрагменты микробных
биополимеров, образующиеся в этом пространстве, поступают в кровь практически
сразу. То есть наличие микробных маркеров в крови отражает состав микробных
сообществ тела человека, независимо от места обитания микроорганизмов или очага
воспаления.
Иначе говоря, измеряя концентрацию микробных маркеров в крови можно
оценивать микроэкологический статус человека в целом.
Однако в норме, то
есть при отсутствии симптомов воспаления или локального инфицирования, их
преимущественным источником является микрофлора кишечника. Поскольку ранее было
показано существование гомеостаза микробных маркеров в крови (Белобородова,
1999), то в свете вышеизложенного можно говорить о гомеостазе микробиоценоза кишечника. Это является еще одним
подтверждением сходства его состава у людей в норме и различия в патологическом
состоянии (Шендеров, 1998). Существенное изменение состава микробных маркеров в
крови по сравнению со статистически обоснованной нормой обнаружено при
перитоните, воспалениях урогенитальных органов и при кожных заболеваниях -
атопическом дерматите, себорейном дерматите, экземах, псориазе, эндокардите,
перикардите и лихорадках неизвестной этиологии.
Гомеостаз пристеночной микрофлоры кишечника предполагает ее постоянство по
отношению к каждодневным диэтическим нюансам. Однако, можно ожидать заметные
сдвиги в составе микроорганизмов кишечника при длительных диэтических
ориентациях: у вегетарианцев или, напротив, у жителей крайнего севера, имеющих
ограничения в растительной пищи. Можно предполагать сдвиги гомеостаза в связи с
географическими, расовыми, религиозными или национальными устойчивыми особенностями питания. Например, у жителей
города Лунда (Швеция) больше
актиномицетов в кишечнике по сравнению с жителями Москвы.
С другой стороны, трудно представить кратковременную (в течение суток,
недели) диэтическую зависимость состава
микрофлоры кишечника. По существу назначения этот орган должен быть
стабильным (гомеостатичным) поскольку определяет композицию множества
химических веществ, поступающих в организм хозяина. Эти вещества, в свою
очередь, определяют качество физиологических процессов всех других органах и
тканях. Они также гомеостатичны, что требует постоянства состава и концентрации
необходимых для осуществления клеточных циклов веществ с одной стороны и
минимума их ингибиторов с другой. Логично
ожидать, что любые существенные отклонения провоцируют патологические
последствия. Но этого не происходит из-за того, что в обед вы ели рыбное или
овощное, а на ужин мясное или творожное. Объяснение тому не трудно получить,
если вспомнить, что на самом деле в кишечник попадает не сами овощи или мясо а
продукты их первичной деградации в кишечнике при действии ферментов в кислой
среде. То есть упрощенно говоря – белки жиры и углеводы. Эти компоненты,
поступающие в тонкий кишечник вместе с секретами пищеварительных желез,
называют химусом. В пределах микробного цикла смены популяций (как раз – от
суток до недели) колебания в составе химуса микробиологически усредняются. Это
обеспечивает равномерное поступление тех двух третей молекул, необходимых для
жизнедеятельности человека, которые образуются за счет микробного метаболизма
химуса. (Гурманы могут быть разочарованы: на самом деле, поглощая деликатесы
они кормят прежде всего не себя, а своих микробов.) Если человек получает
достаточно разнообразной пищи – его клетки имеют необходимый для нормального функционирования набор
химических веществ.
Можно сказать, что рациональпое питание
человека в значительной степени равно рациональному питанию микробов кишечной
стенки.
Длительный дефицит каких либо функционально важных продуктов,
равно как избыток вредных, или ухудшение качества пищи – причина дискомфорта,
снижения качества жизни вплоть до патологических изменений тканей и органов и уменьшение
продолжительности самой жизни.
Однако, всякое микробное сообщество субстратспецифично, - его состав
зависит от наличия питательных веществ в месте обитания. Применительно к
кишечнику и диете это означает что устойчивая смена потребляемой пищи (смена диет) должна приводить к сдвигу в
гомеостазе микрофлоры кишечной стенки. Например, переход на растительную пищу
должен проявиться в снижении доли пептолитических видов микроорганизмов
(расщепляющих белок), за счет конкурентного увеличения доли целлюлолитиков и
других групп микробов, утилизирущих полисахариды. Преобладание углеводов в
рационе вегетарианца способствует увеличению их популяции. Далее по
биохимической цепочке в организме-хозяине происходят определенные сдвиги на
уровне клеточного метаболизма, которые могут снимать клинические проявления,
если они имели место при прежней диете. Равно как и вызывать их при неразумном
применении диет, голодания, чрезмерного употребления антибиотиков,
некачественных пищевых добавок. Отсюда вывод: знание реального состава
микрофлоры кишечника (кишечной стенки, но не фекалий!) и его мониторинг должны
быть полезными для научного обоснования и практической эффективности
регулирования комфортности жизни, профилактики и лечения заболеваний методами
науки диетологии.
Сведения о микрофлоре кишечника, получаемые при бактериологическом анализе
фекалий, ограничены по числу контролируемых видов и точности определения в силу
отсутствия возможностей культурального метода исследования с одной стороны и
естественных колебаний их состава в
зависимости от диеты, возраста, пола и других факторов. Например, вариации в
составе микроорганизмов кишечной стенки разных людей в норме не превышают 50% относительных
по отдельным видам и менее 20% по сумме, тогда как в фекалиях субъективные
отклонения в концентрации составляют порядок величины по суммарной
биомассе и два порядка по отдельным видам. Корректная интерпретация
данных в таких условиях требует по крайней мере большого опыта и интуиции.
Процесс – подобный воссозданию шедевра классика литературы по содержимому его
мусорной корзины.
Такая нестабильность биомассы микроорганизмов и их состава в фекалиях
является следствием поддержания гомеостаза пристеночной микрофлоры. Все лишнее
– избыточный рост микробов, транзиторные микробы, неусвоенный химус вместе с
потоком мукоза является естественным стоком кишечника, который и формирует
фекалии. То есть фекалии – тот буферный резервуар, в который осуществляется
сброс излишней, непропорциональной по отношению к гомеостатичному сообществу
кишечной стенки, микрофлоры и не принятых к транспорту через слизистую оболочку
кишечника компонент химуса и отработанного мукоза с метаболитами
микроорганизмов, не угодных макроорганизму.
Как известно, лечение диетой применяют для нормализации микрофлоры при заболеваниях
желудочнр-кишечного тракта, как дополнительную терапию при других патологиях
или как средство достижения определенного качества кожи, поддержания
стабильного веса и физической формы. Обычно для этого применяют натуральные
средства и рецепты, уходящие корнями в опыт древних предков. Но с середины
прошлого века в развитых странах широкое применение для этих целей обрели
пищевые добавки как натурального происхождения, так и полусинтетические или
синтетические. В быт прочно вошли биотехнологические кисломолочные продукты и
препараты медицинского назначения, содержащие живые или убитые микроорганизмы
не традиционных видов и их композиции. Кроме
того, быстрыми темпами развивается индустрия производства пищевых волокон,
препаратов полиненасыщенных жирных кислот и других полезных, несомненно,
продуктов так называемого функционального питания. Это предлагается взамен
дефицита соответствующих природных продуктов, который образовался за счет
исключения из рациона человека индустриального общества многочисленной группы
растений, грубой натуральной пищи, на которой два миллиона лет формировался
кишечный микробиоценоз Homo sapience – человека разумного. Это относится в значительной
мере к ботаническому разнообразию первобытного человека, употреблявшего «вершки
и корешки» лесного и лугового растительного мира. Вряд ли его можно восполнить
пищевыми добавками, которые есть суррогат естественного сырья, зачастую
получаемого из отходов производства. Всякая технологическая (химическая,
термическая, механическая, биологическая) обработка естественного сырья,
направленная на получения некого целевого продукта, приводит к потере других полезных веществ, а
нередко – самого продукта. Кроме того, особенно опасны неконтролируемые
побочные компоненты, образующиеся в процессе производства, способные принести
вред здоровью. Так что, созданная за миллион лет пищевая детерминанта кишечной
микробиоты вряд ли пострадала за сотню лет индустриализации и урбанизации
жизни. Тем более, что подавляющая часть населения планеты, обитающая в сельских
местностях, или в развивающихся странах до сих пор употребляет натуральную
пищу. Сокращение его ботанического разнообразия пока не выглядит в историческом
смысле фатальным. Во-первых по факту продолжения увеличения средней
продолжительности жизни от примерно тридцати лет у пещерного человека до 40-50
в средние века и 60-70 в наше время. Отсюда видно, что дело не в ботаническом
разнообразии и грубой пище, а
благосостоянии популяции. Можно и в наш век назвать народности, живущие
растительной пищей и охотным промыслом. Нетрудно догадаться, что их здоровье и
продолжительность жизни значительно меньше чем жителей развитых экономически
стран. Выходит, в Японии самая высокая
продолжительность жизни не потому, что там наивысший уровень потребления пищевых
добавок, а потому, что ее жители одни из самых состоятельных в мире и могут
себе позволить прежде всего употреблять в пищу разнообразные растительные,
животные, - особенно море-продукты (причем, что важно, свежие!). Если вам не хватает 3- или 6- омега-полиненасыщенных
кислот - полезнее ввести в рацион печень
трески или другие морепродукты с высоким содержанием этих веществ, чем покупать
в аптеке суррогатные препараты. Лучше употреблять в пищу натуральный виноград,
если вам позволяет достаток, чем пополнять дефицит пищевых волокон, покупая
патентованные пищевые волокна, приготовленные из виноградных выжимок - отходов
виноделия.
Еще один важный аспект пищевых добавок – их химическая и биологическая
безопасность. Безопасность традиционной природной пищи человек обеспечил своим
трагическим опытом, например, отсортировав ядовитые растения от не ядовитых.
Такой способ оценки токсичности пищевых добавок в 21 веке неприемлем.
Необходимо исследование их состава и свойств не только в процессе разработки –
но и в процессе производства. Если на первой стадии это осуществляется, то на второй, как правило
– отсутствует. Нет технологического контроля биологически активных препаратов
живых микроорганизмов в пробиотиках или заявляемых в аннотации пищевых добавок
активных ингредиентов. Это дорого, потому что требует высоких аналитических
технологий. Нет генетического или масс-спектрометрического анализа микробных
композиций и примесных видов в пробиотиках и молочно-кислых продуктах или спектроскопических методов в количественном
подтверждении целевых веществ в синтетических продуктах функционального питания.
Технологии молекулярных исследований биологических веществ хорошо развиты как
раз в Японии. Возможно, они могут себе позволить контролировать состав и
структуру биологически активных веществ в БАДах. Нам попадались препараты
морских микроводорослей с заявленным содержанием омега-полиненасыщенных кислот,
которые их не содержали. Масс-спектрометрический анализ показывал, что в
пребиотик вместо лактулозы введен сходный по атомному составу, но отличающийся
структурно дисахарид лактоза. Есть пищевые добавки с декларированным
содержанием растительных флавоноидов, которые таковых не содержат. Есть казусы,
происходящие от неосведомленности производителей
добавок и их медицинских экспертов. Например, препарат флавоноидов,
стимулирующих рост кишечных бактерий предлагается в качестве антимикробного
средства и приводится пакет заключений из клиник, это подтверждающий.
Оказывается, это действительно так, но препарат не содержит флавоноидов, а
содержит технический антисептик, не прописанный в аннотации. Еще хуже обстоит
дело с производством пищевых добавок из отходов производства. В 80-е годы
прошлого века это было государственной политикой (кормовой белок, дрожжевые
автолизаты и пр.). Впоследствии это направление было закрыто из-за
отрицательного опыта их использования в животноводстве и птицеводстве,
рыбоводстве. В девяностые годы оно снова возникло как способ выживания
коллективов биотехнологических институтов. Там, где работали грамотные и,
главное, искусные химики – получали хорошие препараты. Например, препарат с высоким
содержанием токоферола из шрота красного горького перца. Но все равно, кроме
10% токоферола, он содержал, по данным хромато-масс-спектрометрии, еще порядка
двухсот веществ, по большей части не известной биологической активности. Можно
полагать, что они, по крайней мере безвредны, так как получены из продуктов,
употребляемых в пищу человеком. Тем не менее, опасность их токсических
проявлений возникает минимум по трем причинам:
Резкого
повышения содержания минорных компонент состава пищевого сырья при
неизбежном технологическом концентрировании целевого продукта
Наличия
продуктов метаболизма гнилостной микрофлоры при использовании несвежего
сырья (что, как правило, имеет место быть)
Изменение
структуры природных веществ под действием химической обработки
Последнее неизбежно при производстве, включающем гидролиз животного или
растительного сырья сильными кислотами или щелочами. Как показывает хромато-масс-спектрометрический
анализ, при гидролизе мясных или рыбных продуктов, кроме двадцати аминокислот,
необходимых человеку, образуется еще десятки аминокислот измененной структуры,
физиологическое действие которых не предсказуемо.
Такого рода БАДы, если и рекомендовать для использования в пищу, то очень
аккуратно, при наличии наукоемких технологий контроля исходного сырья и
конечного продукта. Видимо это не реально. По крайней мере – пока. Поэтому
возвращаемся к исходной мысли: чтобы быть здоровым и прожить долгую жизнь, надо
разнообразно, но умеренно питаться натуральными свежими продуктами.
Синтетическая пища – это скорее для экстремальных ситуаций – тюбики для
космонавтов межпланетных кораблей, ограниченных габаритов. Да и то, гуманные
фантасты проектируют в своих романах большие корабли для межзвездных полетов с теплицами
для овощей и фермами для скота. А пока нам рановато переходить на пищевые
волокна под соусом синтетических аминокислот.
Лучше с ним не быть. Как говорят врачи – болезнь легче предупредить, чем
вылечить (если знать как предупредить). Точно также проблематична сейчас
проблема коррекции дисбактериоза кишечника. Врачей специалистов в коррекции
дисбактериоза по существу нет и не может быть пока у нас нет рутинного метода
его анализа. Сейчас это искусство терапии вслепую. Масс- спектрометрический
метод может претендовать на метод массового контроля пристеночной микробиоты
кишечника по микробным маркерам в крови. Во-первых, другого способа нет.
Во-вторых, экономически это оправдано тем, что метод оказывается дешевле
распространенного сейчас культурально-биохимического. Предлагаемые на рынке
системы для идентификации микроорганизмов (MIS – microbial identification system) стоят от 50 до 120 тыс долларов США и требуют
ежегодно асигнований в 60 тыс $ на расходуемые материалы в виде наборов для
культивирования и тестирования. Современный хромасс стоит 65-80 тыс $ при
ежегодных расходах на эксплуатацию не более 5 тыс $. Сюда входят более дешевые химреактивы, разовая посуда,
прокладки, пипетки, шприцы, а культуральные среды и тестовые субстраты не
нужны, так как микробы определяют непосредственно в клиническом материале по
молекулярным признакам. Это при том, что ГХ-МС метод определяет, причем
количественно, гораздо более широкий круг микроорганизмов, в том числе не
культивируемых и не идентифицируемых традиционным методом. Но они как раз и составляют основную часть
микрофлоры кишечника, которую надо регулировать при дисбактериозах, это –
эубактерии, клостридии, аэробные актиномицеты, лактобациллы и бактероиды. В-трерьих,
есть прецедент широкого использования ГХ-МС как метода рутинного анализа в
процедуре антидопингового контроля спортсменов. Национальные лаборатории (в том
числе и российская) имеют в своем арсенале до десятка ГХ-МС систем стоимостью
от 100 до 700 тыс $ каждая. В практике средней клиники одного хромасса достаточно
для замены (или дополнения) традиционной бактериологической службы. Первая в
мире лаборатория, использующая ГХ-МС систему в диагностике микст-инфекции при
эндокардите и послеоперационных осложнениях в кардиохирургии, создана в НЦ ССХ
им А.Н.Бакулева в Москве проф. Н.В.Белобородовой.
Итак, как предупредить дисбактериоз? Ответ прост. Прежде всего, важно
правильно родить ребенка и натурально вскормить. Затем разнообразно питать всю
жизнь, избегая сильных стрессов и не допуская злоупотребления антибиотиками и
вредными привычками. Только и всего.

Рис 1. Состав микроорганизмов переходного стула новорожденного (3 суток)
в точности совпадает с вагинальной
микрофлорой матери.
Естественный родовой процесс предпочтителен кесареву сечению, поскольку оказывается, что первичное заселение (инокуляция) микроорганизмами кишечника новорожденного происходит при прохождении родовых путей матери. Это по существу вагинальная микрофлора женщины. Ее состав в части доминирующих микроорганизмов (по данным масс-спектрометрии) совпадает с составом фекалий (переходного стула ) младенца третьего дня жизни (рис ..). До тех пор его кишечным отправлением является так называемый меконий, черная смолоподобная масса, содержащая жизнеспособные микроорганизмы из состава кишечных: пептострептококк, клостридии, лактобациллы, аэробные актиномицеты среди доминирующих видов, а также руминококки, стрептококки, эубактерии, стрептококки и микроскопические грибы. Бифидобактерии и семейство кишечных палочек (Enterobacteriaceae) не обнаружены. Это исследование, наряду с известными публикациями по микрофлоре мекония, содержит намек на заселение микробами кишечника плода уже при внутриутробном развитии через известный эффект транслокации микроорганизмов с кровью матери. Состав фекалий на пятый день жизни уже близок по многим показателям к норме двенадцатилетнего подростка. Но часть из них продолжает нормализоваться до полугода. В этот период на кишечной стенке растет численность бифидобактерий и эубактерий, снижается до уровня нормы взрослого количество лактобацилл, энтеробактерий, кокковых форм и микроскопических грибов.

Рис.2. Становление микробиоценоза ребенка происходит примерно в течение полугода. Численность энтеробактерий уменьшается, а бифидобактерий увеличивается до взрослой нормы.
( Часть данных мониторинга методом ГХ-МС микробных маркеров в крови)
Эти данные свидетельствуют о том, что в период первой недели жизни и первых шести месяцев новорожденному должны быть созданы все условия для нормального становления микрофлоры кишечника.
Поскольку
микрофлора родовых путей матери является, на языке микробиологов, инокулятом
или закваской будущей микрофлоры ребенка, то логично полагать необходимым
поддержание ее нормальной в процессе беременности и родов. Нормальность
микрофлоры означает гомеостатичность ее качественного и количественного состава
при «своих» штаммах, не вызывающих реакции иммунной системы (воспаления). Это
никак не означает стерильности, поскольку все слизистые оболочки и кожа
организма человека закономерно содержат микробную биопленку. По аналогии с
нормальной микробиотой кишечника микроорганизмы биотопов половых путей женщины
также выполняют важные физиологически функции и
участвуют в поддержании гомеостаза макроорганизма. Поддержание
относительно стабильного качественного и количественного состава микробиоценоза
влагалища имеет важное значение в обеспечении нормального физиологического
статуса женского организма. Нормальная микробиота - тот первичный неспецифический
барьер, лишь после прорыва которого инициируется включение всех последующих
неспецифических и специфических факторов защиты макроорганизма. Она выступает
как чуткий индикатор физиологического состояния макроорганизма в зависимости от
воздействия на него различных факторов. Обобщенные сведения по вагинальному
микробиоценозу можно найти в фундаментальном руководстве для клиницистов Manual of Clinical Microbiology (1991).Нормальная
влагалищная бактериальная флора представлена разнообразными видами
микроорганизмов, многие из которых еще не идентифицированы.
Количественный
бактериологический анализ
вагинального сообщества здоровых женщин
показал, что в 1 г вагинальной жидкости содержится 108 клеток
аэробных и 109клеток анаэробных бактерий (Hill G.B., 1984; Bartlett J.G., 1977; 1984). Ведущими микроорганизмами являются
Lactobacillus, Peptococcus, Bacteroides, Staphilococcus epidermidis,
Corinebacterium spp., Peptostreptococcus spp., Eubacterium. Этот список отражает ранговое расположение доминирующей микробиоты, исходя
из концентраций более 105 КОЕ/г. При изучении состава аэробной и анаэробной
микрофлоры на протяжении беременности и на 3-й и 6-й неделях после родов многие
авторы прослеживают тенденцию нарастания количества лактобактерий в течение беременности
при снижении анаэробных видов. Это свидетельствует о том, что в процессе
беременности происходит угнетение влагалищной микробиоты, за исключением
лактобактерий. В послеродовом периоде численность грамотрицательных
факультативных палочек и большинства анаэробных видов возрастает. Растет
количество коринебактерий , E. сoli, стафилококков, стрептококков, а количество
лактобактерий и бифидобактерий уменьшается. Во влагалище у здоровых девочек до
момента менархе микрофлора представлена в основном пептококками,
пропионибактериями, бифидобактериями, эубактериями, реже бактероидамии; у
женщин в период менопаузы и постменопаузы также доминируют Peptococcus, Peptostreptococcus anaerobius, Bacteroides, Eubacterium, тогда как содержание лактобактерий резко уменьшалось.
Эти процессы в микробиоценозе влагалища связаны со сниженным уровнем эстрогенов у девочек и у женщин
пострепродуктивного возраста.
Большинство патогенных организмов являются
компонентами нормальной микрофлоры человека. Данные института Пастера показали,
что из 6603 женщин, которые обратились с жалобами на выделения из половых
путей, банальная инфекция (стафилококки, стрептококки, кишечная палочка и др.)
была выявлена у 35,2% пациенток, Candida аlbicans - у 25% женщин, бактериальный вагиноз - у 17,4%,
а далее следовала трихомонадная инфекция (8,2%), Neisseria gonorrhoeae (3,2%). Только у 10% женщин выявлена нормальная
микрофлора влагалища. Наиболее частые возбудители (по литературным данным), представляющие как
локализованную, так и генерализованную инфекцию - патогенные стафилококки,
стрептококки, Pseudomonas aeurogenosa,
Proteus, E.coli, Klebsiella, Serratia, Enterobacter, Flavobacterium meningosepticum, Neisseria meningitidis.
Кроме того, возможно наличие микроскопических грибов (Hamman R.,1982), а также Peptostreptococcus, ассоциированных с Bacteroides и Trichomonas (Brockman J.,1979). У пациенток венерологических клиник
определяли Candida, Chlamidia, Trichomonas, Mycoplasma, которые обычно сопутствуют N.gonorrhoae. У молодых женщин чаще выявлялись Chlamidia trachomatis, у
женщин старшего репродуктивного возраста – Trichomonas vaginalis (Person K., 1979).
Основными возбудителями заболеваний, передающихся половым путем (ЗПП),
являются Neisseria gonorrhoae, Chlamidia trachomatis, Ureaplasma urealyticum,
Mycoplasma hominis, Trichomonas vaginalis, Candida albicans и вирус простого герпеса.
Результаты статистического анализа распределения
концентраций жирных кислот микробного происхождения в моче, эякуляте и
вагинальном содержимом (метод ГХ-МС) свидетельствует о гомеостазе маркеров
микроорганизмов в норме, а следовательно, и соответствующего микробиоценоза
локусов урогенитального тракта (УГТ). Статистическая обработка данных позволила
выявить два множества (кластера) значений концентраций микробных ЖК. Один из
них с меньшим значением средних величин можно отнести к норме, а другой – с
высоким средним уровнем – к патологии, т.е. воспалению. Гомеостаз – понятие
физиологическое и должно предполагать постоянство как самого микробного
сообщества локуса, так и состава и свойств его местообитания. Действительно, в
формировании этих свойств естественным образом
должны участвовать и микроорганизмы, которые, так же как и в кишечнике,
производят многочисленные биологически активные продукты: ферменты, антибиотики
(актиномицеты, стрептомицеты, грибы), регуляторные факторы, витамины но также и
токсины, факторы патогенности и пр. Они участвуют в поддержании рН среды и
баланса микроэлементов.
Полученные методом ГХ-МС данные подтверждают
современное представление об инфекциях УГТ как о полимикробном воспалении.
Более того, данные показывают, что ни один из контролируемых таксонов
микроорганизмов не сохраняет свою концентрацию в пределах нормы при
воспалениях. Здесь понятие таксон может иметь ранг семейства или рода как
правило. То есть, на самом деле видовое разнообразие микробиоценоза УГТ в
несколько раз шире (за счет видового разнообразия микроорганизмов в роду или
семействе), чем мы видим по протоколу исследований. Следует отметить, что оно
напоминает кишечную микробиоту своим качественным составом, в том числе
анаэробами, среди которых фигурируют клостридии, бактероиды, бифидобактерии,
лактобациллы, фузобактерии, пептострептококки и эубактерии, обитающие в
кишечнике. Такую связь отмечают авторы научных публикаций и практикующие врачи.
Полученные нами данные еще раз свидетельствуют о том, что причину воспалений
органов малого таза надо искать еще и в кишечнике.
Не лишено смысла рассматривать микробное соообщество любых слизистых
оболочек в определенной мере подобной кишечнику организованной биопленке.
Поводом к тому является стабильность состава каждого из этих микробиоценозов:
гомеостаз микробных маркеров имеет место не только в крови (Белобородова,
2000), но и в моче, вагинальном содержимом женщин и эякуляте мужчин (Крымцева,
2003). Их концентрация, измеренная методом ГХ-МС постоянна у здоровых людей,
селективно и специфически меняется при воспалениях и возвращается в прежнюю
норму после адресного по отношению к агентам воспаления лечения. Можно
полагать, что и в УГТ мы также имеем дело с биопленкой, включающей в
подавляющем большинстве компоненты автохтонной микробиоты, присущей человеку.
Она специфически переходит в патогенное состояние, включающее набор постоянных
агентов (Pseudonocardia, Fusobacterium/Haemophylus, Klebsiella, Streptococcus,
Staphylococcus epidermidis и Clostridium perfringens), и прочих членов сообщества, активных
периодически. При таком представлении о микробиоценозе становятся понятными
трудности, возникающие при лечении кандидоза, хронических вагинитов,
пиелонефритов, уретритов и простатитов. Первой причиной неудач является упорная
диагностика модных инфекций (хламидии, микоплазмы, уреаплазмы, гарднерелла,
мобилункус, герпес-вирус) при игнорировании патогенного потенциала автохтонной
микрофлоры. Второй причиной являются известные трудности в доставке лекарства к
очагу воспаления при болезнях почек, мочевого пузыря и простаты. Третья, пока
мало известная клиницистам причина – коллективная сопротивляемость антибиотикам
и другим воздействиям (quorum sensing) организованной в
биопленку микробиоты локусов.
Приведенные выше соображения показывают, что микробиота слизистых оболочек
половых органов женщин не может не являться физиологическим партнером
организма-хозяина. Она гомеостатична и играет положительную роль в обменных
процессах на слизистой оболочке и защите от внешних патогенов. В то же время
она проявляет и враждебные по отношению к хозяину функции, если состав
микробиоты нарушен и токсинообразование, характерное для большинства
представителей нормофлоры, становится клинически значимы и может угрожать
здоровью женщины. Более того, оно может угрожать и главной физиологической
функции женских половых органов – репродуктивной. У женщин с проблемами
беременности или неудачами ЭКО методом ГХ-МС выявляется существенное превышение
нормы «скрытыми» (от рутинных методов) компонентами нормофлоры: Clostridium perfringens, Helicobacter pylory, Streptomyces,
Eubacterium.
Clostridium perfringens образует как минимум 12 идентифицированных
токсинов и энтеротоксин.
Мишени для основных токсинов – биологические мембраны в различных тканях.
Поражения обуславливают ферментативные процессы, катализирующие гидролитическое
расщепление и нарушение клеточной проницаемости с последующим отеком и
аутолизом тканей, характерными для газовой гангрены.
Helicobacter pylory ,
проникая через слизь, прикрепляются к эпителиальным клеткам, проникают в железы
слизистой оболочки. ЛПС микроорганизмов способствует миграции нейтрофилов и
развитию острого воспаления. Под действием бактериальной уреазы мочевина
превращается в аммиак, повреждающий слизистую оболочку.

Фото 7. Хеликобактер в вагинальном содержимом
(предоставлено доктором В.Дворянчиковым).
Eubacterium – родственные клостридиям
микроорганизмы, являющиеся одними из основных обитателей кишечника. Условные патогены с развитой системой видов и
штаммов с универсальными свойствами. В том числе для них характерно
индуцирование продукции провоспалительных цитокинов и TNF-alfa, а также противовоспалительного цитокина IL-10 (как ЛПС или
клеточные токсины Грам+ патогенов). Это обуславливает их участие в патологиях
тяжелых заболеваний, таких как, средиземноморская семейная лихорадка,
эндокардит, врожденный порок сердца, кожные и кишечные патологии, связанные со
сложным изменением концентрации их видов в биотопах.
Streptomyces - аэробные актиномицеты, широко распространеные в
окружающей среде, в том числе на стенах сырых помещений, а также в организме
человека. Токсигенные штаммы выделяют токсин валиномицин, разрушающий
митохондрии клеток млекопитающих (Anderson, 1998).
При наличии такого рода микроорганизмов в
детородном органе по отдельности, а тем более при одновременном присутствии,
вряд ли будет возможным развитие оплодотворенной яйцеклетки в полноценный плод
и нормальное протекание беременности.
Обнаружены маркеры Neisseria и сопутствующей в
таких случаях анаэробной микрофлоры (пептострептококк, бактероиды, фузобактерии,
превотелла, Selenomonas). В то же время занижено содержание лактобацилл,
бифидобактерий, некоторых клостридий, руминококков, актиномицетов, части
эубактерий и других микроорганизмов нормофлоры - вагинальный дисбактериоз.
Превалируют аэробные актиномицеты со
стрептококками, бифидобактериями и руминококками. То есть сильно развиты
кокковые формы, среди них - Rhodococcus equi, который рассматривают как
внутриклеточный условный патоген (аналог гонококка, но менее вирулентный -
обычно встречается у мужчин при простатите). Превышают норму некоторые другие
бактерии, среди которых заслуживают внимания два вида клостридий.
Ложный кандидоз. Похожую клинику дает Clostridium perfringens при отсутствии Candida albicans. Превышают норму маркеры анаэробных бактерий C. perfringens, Propionibacterium и
Butyrivibrio. Завышено содержание
маркера Staphylococcus
epidermidis.
Энтеробактерии. Эндотоксинемия. Ведущими
микроорганизмами являются грамотрицательные микроорганизмы, преимущественно
сем. Enterobacteriaceae, которые создают высокие концентрации эндотоксина в локусе и в крови.
Микоз, без участия кандиды. Существенно
превышают норму маркеры микроскопических грибов, продуцирующих кампестерол и
ситостерол, а также Staphylococcus aureus и клостридии Clostridium propionicum
и Clostridium perfringens. Ниже нормы
количество многих бактерий, в том числе бифидобактерий и лактобацилл
(дисбактериоз).
Ведущая микрофлора представлена бактериями Clostridium perfringens и микроскопическими грибами Candida albicans при наличии Streptococcus (Streptococcus oralis) и грамотрицательных микроорганизмов родов Klebsiella, а также анаэробов Eubacterium.
Заболевания урогенитальной сферы
мужчин - уретрит, простатит, орхит до сих пор занимают важное место в проблеме
здоровья и продуктивности человека. На рубеже нового тысячелетия проблема
простатита требует нового осмысления и вызывает необходимость поиска
рациональных подходов к его диагностике и лечению. Острый и хронический
бактериальный простатит занимает два первых места в классификации простатитов
Нацинального института здоровья США. Доля инфекционного простатита при этом
растет в хронологическом порядке и в
настоящее время составляет до 70% - 90% по оценкам разных лабораторий. Однако
определение возбудителя, а тем боле микст-инфекции при простатите (уретрите,
орхите, мужском бесплодии) представляет проблему при клиническом или
амбулаторном бактериологическом обследовании. Многие микроорганизмы, например,
анаэробы и другие трудно культивируемые (коринеформы, микобактерии, микроскопические
грибы) избегают детектирования современными методами клинической микробиологии.
Их присутствие в семени и жидкости простаты становится известным лишь благодаря
уникальным научным исследованиям, доступным специализированным научным
лабораториям. Результатом являются, соответственно, единичные публикации в научной периодике. В
изязвлениях мужских половых органов найдены аэробные и анаэробные бактерии, Mycoplasma, Нaemophylus ducrey, Treponema pallidum, Herpes simplex virus, дрожжи и нитчатые грибы. В семени мужчин,
страдающих бесплодием, обнаружены E.coli, Staphylococcus, Pseudomonas, Klebsiella, Enterobacter, Bacillus, Neisseria, Corinebacterium, Micrococcus, Proteus, Achromobacter, а также микроскопические грибы. При инфекционном
простатите в разных исследованиях выявлены представители семейства Enterobacteriaceae, бактерии рода Pseudomonas, энтерококки (Enterococcus faecalis, E.faecium и другие), Staphylococcus aureus, Chlamydia trachomatis, Corynebacterium, Staphylococcus, Peptostreptococcus, Streptococcus, and Escherichia, Flavobacterium spp., Pseudomonas testosteroni.
Исследование ДНК секрета и биоптатов простаты свидетельствует о наличии в них
микроорганизмов, отличающихся от микробиоты кожи и прямой кишки, и,
следовательно, не обнаруживаемых традиционными методами. Действительно,
генетическим методом удалось определить в семени наличие 15 видов необычных
анаэробов родов Peptostreptococcus, Prevotella, Corinebacterium, Rubrivirax, Actinobacillus, Veilonella и Eubacterium, а также трех аэробов: Streptococcus salivarius, S.pneumoniae и Burkholderia picketii. Как
неожиданность воспринимается обнаружение в секрете простаты превалирующего
количества недектируемых в обычной клинической практике коринеформных бактерий,
причем в сложном сообществе с Staphylococcus, Peptostreptococcus, Streptococcus и Escherichia, состав которого различен у разных пациентов. Кроме того, обнаружены микробные ассоциации и у здоровых мужчин,
однако иные, чем у больных и в меньшей концентрации. Следует отметить важное для диагностики
инфекции обстоятельство, которое состоит в том, что микробные колонии могут
быть локализованы в полисахаридных капсулах. Как показали
электронно-микроскопические исследования, они покрывают стенки простаты и
протоки при хроническом бактериальном простатите.
В таких случаях бактерии не могут
выходить из капсулы и, следовательно, быть обнаружены методами, использующими
выделение целых микроорганизмов. Однако их присутствие можно выявить и
количественно оценить путем детектирования микробных маркеров - малых молекул,
составляющих материал клеточной стенки микроорганизмов - бактерий, грибов,
простейших, метаболитов вирусов в семени или секрете простаты. Тканевые, клеточные и капсульные барьеры не
являются преградой для таких молекул - они, в отличие от микробных клеток,
свободно их проходят и могут быть измерены методом ГХ-МС.
Обширная колонизация генитальных органов и
мочевыводящих путей предполагает множественность бактериальных агентов
воспалений. Ясно, что успех лечения заболеваний микробного происхождения
зависит от эффективности диагностики инфекции. Однако методы
микробиологического анализа, применяемые в клиниках и медицинских центрах,
позволяют одновременно определять один
или несколько организмов из многих видов,
агентов внешней инфекции или колонизирующих организм человека и
являющихся потенциальными патогенами.
Уникальные возможности в этом отношении дает метод
ГХ-МС. В отличие от других методов он является количественным, т.е. позволяет
определять точно и воспроизводимо во времени количество микробных клеток
каждого микроорганизма, колонизирующего область простаты. Сотни измерений
концентрации микробных маркеров, проведенные нами в норме и при воспалительных
процессах в генитальных органах, при соответствующей статистической обработке современными
методами, позволили определить клинически значимые концентрации маркеров. Это
позволяет фиксировать переход соответствующего микроорганизма из состояния
симбионта в состояние патогена и применить к нему методы антимикробной терапии.
По порядку величины уровень клинически значимых концентраций маркеров
соответствует известным измерениям и составляет 104-105
клеток в пробе.

Рис.3. Распределение концентраций 10-метил-гексадекановой
кислоты - маркера Rhodococcus equi в эякуляте мужчин. Норма – красный столбик слева.
Рис. 4. Матрица микробного сообщества зоны половых
органов больных простатитом. Реконструирована по данным ГХ-МС анализа микробных
маркеров в эякуляте. По вертикали – 50 микробов, населяющих половые органы
мужчин, по горизонтали – 16 из 100 обследованных пациентов. В ячейках
концентрация микробов. Желтым цветом выделены ячейки с превышением нормы в два
и более раз. Матрица преимущественно
полосатая – избыточный рост одних и тех же микробов у всех (или большинства)
обследованных.
Масс спектрометрическое исследование 300 пациентов подтверждают приведенные
выше данные по видовому составу микрофлоры при заболеваниях УГТ у мужчин.
Новизна подхода состоит в одновременном количественном анализе ее изменений в
патологии в сравнении с нормой и обнаружении ряда новых микроорганизмов из
числа некультивируемых. Выявлено, что при простатите существенно увеличивается
концентрация аэробных актиномицетов (Rhodococcus equi – рис…- и Streptomyces spp), анаэробов рода Eubacterium и
микроскопических грибов, продуцирующих кампестерол и ситостерол. Специфичность
статистических изменений легко проследить на матрице изменений микрофлоры
половых органов мужчин (рис…), из которой видно, что десять микробов из числа
50 контролируемых почти в 100 % случаев (n=100) превышают уровень клинической значимости
(ячейки выделены желтым цветом). Это Streptomyces, Fusobacterium/Haemophylus, Rhodococcus equi, Streptococcus, Enterobacteriaceae spp, Staphylococcus spp, Enterococcus, Eubacterium и микроскопические грибы. Остальные микробы более или менее часто
сопутствуют этой основной группе, представляющей специфическую смешанную
«инфекцию» при простатите. Инфекцию в кавычках, потому что все перечисленные
виды микроорганизмов являются представителями автохтонной (или индигенной) – то
есть присущей человеку микрофлоры. Увеличение их концентрации в месте обитания
вероятно (но не обязательно) связано с их переходом в патогенное по отношению к
хозяину состояние. Интересно обнаружение
Rhodococcus equi (лошадиный
розовый кокк – в переводе с латыни) – микроорганизма, изначально обнаруженного
в лошадиных фекалиях. Кроме лошади, он широко распространен в почвах. Наверное,
не удивительно, что он прижился и в человеке, вследствие его многовекового
соседства с этим домашним и боевым животным. Есть основание предполагать
существенную роль родококков в воспалении, поскольку они являются
условно-патогенными внутриклеточными паразитами. И в этом свойстве можно
усмотреть их аналогию гонококку.
Несколько слов о матрице. Она представляет собой наглядное статистическое
описание микробной этиологии воспалительного процесса или дисбактериоза.
Возможно, она дает информацию врачу о выборе универсальной схемы лечения, если
нет под руками масс-спектрометра.
Стрессовые отклонения от режима рационального питания детей все чаще
приводят к нарушению обменных процессов в кишечнике, которые вместе с другими
факторами способствуют возникновению атопического дерматита или в экстремальной
ситуации язвенного некротического энтероколита. Последнее заболевание в своей этиологии
связано с избыточным ростом в кишечнике клостридий перфрингенс, хеликобактера и
особенно стрептомицетов, токсическое действие которых оправдывает его название.
Атопический дерматит является ярким примером связи состояния кожных
покровов с микрофлорой кишечника. Обследование методом ГХ-МС микробных маркеров
пятидесяти детей в возрасте от одного месяца до 12 лет (совместно с Мазитовой
Л.П. и Текучевой Л.В., ЦНИКВИ им. Короленко) выявило систематический избыточный рост в тонком кишечнике
эубактерий, клостридий перфрингенс, клостридий дефициле и стрептомицетов, а
также превотелл, сфингомонад, энтеробактерий, пропионобактерий, стафилококков,
бацилл, анаэробного пептострептококка, хеликобактера. В статистической матрице
они дают желтые полосы напротив соответствущих микроорганизмов по всей ее
ширине. Отдельными ячейками выделены эпизодические сопутствующие
микроорганизмы. В некоторых случаях концентрация микроорганизмов у больных ниже
нормы – соответствующие ячейки в матрице помечены бирюзовым цветом. При этом суммарная концентрация
микроорганизмов во всех случаях выше нормы

Рис. 5. Хроматографические пики маркеров Clostridium perfringens (10-гидрокси-олеиновой и 10-гидрокси-стеариновой кислот – два пика справа) существенно выше у детей с атопическим дерматитом (зеленая, верхняя хроматограмма) по сравнению со здоровыми (нижняя, черная хроматограмма).

Рис 6. Микробная
матрица при атопическом дерматите. Много микробов приобретают клинически значимые
концентрации у всех больных. Кроме того, много частых сопутствующих
микроорганизмов. Возможно, с этим связана атопика - неопределенность
локализации и характера клинических проявлений. Матрица полосато-пятнистая:
полосы – избыточный рост микробов, специфичных для данного заболевания. Пятна –
эпизодический избыточный рост микробов у
части пациентов.
Специфика микробной матрицы при АД состоит в том, что хотя многие микробы
приобретают клинически значимые концентрации у всех больных, наблюдается много частых появлений сопутствующих
микроорганизмов. Возможно, с этим связана атопика - неопределенность
локализации и характера клинических проявлений этого заболевания.
Результаты исследования изменений состава микроорганизмов в кишечнике при
атопическом дерматите свидетельствуют, что здоровье кожи напрямую связано с его
стабильностью. Что является первичным, а что вторичным в этом взаимоотношении
еще предстоит выяснить. Тем не менее, ясно, что нормализация кишечного биоза
может облегчить лечение заболевания.
Впоследствии было найдено, что и при других кожных заболеваниях происходят изменения в составе микробиоты тонкого кишечника. В стадии завершения работа по себорейному дерматиту (совместно с акад. Учайкиным В.Ф. и кмн Полеско И.В., РГМУ). Это распространенное заболевание сопровождается иными изменениями кишечной микрофлоры, чем при атопическом дерматите, но также одинаковым у исследованной группы пациентов. При себорее тоже растет численность аэробных актиномицетов, но уже не стрептомицетов, а псевдонокардий, родококков и других. Тоже повышается концентрация клостридий, но не перфрингенс, а других: видов рамозум, пропионикум и гистолитикум. Одновременно уменьшается численность эубактерий, бифидобактерий и лактобацилл.

Рис. 7.
Диаграмма и таблица изменений численности части микробиоты кишечника,
типичных для себореи.
Это распространенное в молодом возрасте заболевание имеет общие корни с себореей, связано с изменением функции сальных желез и сопутствующем изменением микрофлоры кожи. Основными бактериальными агентами акне и себореи считаются микроскопические грибы рода Malassesia, бактерии Propionibacterium acnes и стафилококки. Метод ГХ-МС позволил подтвердить и расширить список микроорганизмов кожи, участвующих в процессе заболевания, а также обнаружить систематические изменения состава микрофлоры кишечника, сходные у обследованных больных (совместно с проф. Самсоновым В.А. и аспирантом Кабаевой Т.И., ЦНИКВИ им Короленко). Действительно, при акне кроме малассезии в коже наблюдается усиленный рост и других микроскопических грибов: кандиды и группы не идентифицированных, но обнаруженных по продукции специфических стеролов – кампестерола и ситостерола. Кроме P.acnes, микроба, видовое определение которого стало названием заболевания, найдены маркеры пропионовых бактерий других видов и морфологически сходных с ними коринебактерий и актиномицетов, которые в сумме также обнаруживают избыточный рост на коже больных. Аналогичным образом оказалось, что стафилококки не являются единственным представителем кокковых форм при акне. К ним следует добавить стрептококки и руминококки.

Рис. 8. Избыточный рост
микроскопических грибов,
альфа-стрептококков и руминококков на коже ряда больных
акне в сравнении с нормой (красный столбик справа).
Для акне, по данным исследования микробных маркеров в крови, в кишечнике специфичен избыточный рост клостридий, бацилл, хеликобактера, некторых актиномицетов и Eubacterium lentum при дефиците других (основных) видов Eubacterium, лактобацилл и коринебактерий. Метод ГХ-МС в современном исполнении обладает способностью разделять сложные органические смеси и одновременно идентифицировать вещества по их масс-спектрам. С его помощью в кожном сале было выявлено 123 составляющих компонента из числа жирных кислот, спиртов и стеролов, входящих в состав восков (эндогенных липидов кожи) и эфиров холестерина, проникающих из кровяного русла и рассматриваемых в патологии акне в качестве экзогенных липидов, способствующих развитию заболевания. К этому следует добавить пул липидных компонентов микроорганизмов, населяющих кожу – еще около 70 микробных жирных кислот, оксикислот и стеринов.

Рис 9. Матрица кожного сала (себума) у больных угревой болезнью. 118
жирных кислот (верхняя половина таблицы) и спиртов (нижняя половина) двадцати
пациентов расположены сверху вниз по мере увеличения длины цепи молекулы. Желтым
цветом выделены ячейки с превышением нормы в два и более раз. Бирюзовым – уменьшение более чем в два раза.
Концентрация бирюзового цвета к низу матрицы показывает уменьшение доли
длинноцепочечных молекул спиртов и жирных кислот, а также преимущественное
уменьшение доли спиртов в кожном сале.
Таким образом, в распоряжение дерматолога предоставляется еще одна матрица, показывающая статистику изменения состава веществ кожного сала при заболевании в сравнении с нормой. Эти данные, наряду с морфологическими и физиологическими характеристиками измененной кожи помогут понять причину заболевания и наметить пути эффективного лечения. Пока можно отметить, что эти данные подтверждают известное уменьшение доли эндогенных липидов (восков) при угревой болезни, а также выявляют новые детали изменений в себуме: уменьшение доли длинноцепочечных жирных кислот и спиртов, существенное снижение содержания специфической кожной ЖК – себолеата и другие.
При алопеции микробное сообщество кожи равно как и микробиота кишечника
претерпевают существенные изменения. Лидерство в избыточном росте на коже
приобретают анаэробы (клостридии группы гистолитикум, анаэробные
пептострептококки, бактероиды) и микроскопические грибы, продуцирующие
кампестерол или ситостерол. К ним присоединяются уже упоминавшиеся в связи с
акне альфа-стрептококки, коринебактерии, стрептомицеты и пропионобактерии. Изменение
численности микроорганизмов в зоне сальных желез составляет величину от 10 до
1000 крат. Разумно предположить, что это обстоятельство препятствует росту
волос, поскольку морфологические изменения в коже приписывают в основном
воспалительным процессам. Последние, как правило, связывают с наличием инфекции
или избыточной колонизацией автохтонной микрофлорой.
При алопеции в кишечнике большинства обследованных обнаруживается избыточный рост суммарной микробиоты, преимущественно за счет микроскопических грибов, продуцирующих кампестерол, эубактерий, бактероидов, клостридий, стрептококков и некоторых актиномицетов.
Рис.10. Микробная матрица
дисбиоза кишечника при алопеции. Желтые полосы относятся к постоянным у разных
пациентов увеличениям концентрации в пристеночном слое тонкого кишечника
микроскопических грибов, эубактерий, бактероидов, клостридий стрептококков и
актиномицетов при суммарном избыточном росте кишечной микрофлоры.
Следует жить. Жить в плодотворном союзе с
микроорганизмами, как это и происходит на протяжении более миллиона лет. Микробное сообщество в составе муцинового
геля слизистых оболочек представляется в
виде многоклеточной псевдоткани
(биопленки) и является жизненно важным органом человека. Как показывают приведенные
здесь примеры состав микроорганизмов биопленки постоянен у здоровых людей и
изменяется при патологических состояниях. Как следствие изменяется доля участия
микроорганизмов в физиологических процессах на слизистых оболочках или коже
организма-хозяина. Возникает дисбаланс в снабжении других органов зависимыми от
микробов веществами, нарушается гомеостаз метаболических процессов,
стабильность иммунной системы. Если возмущение превосходит компенсаторные
ресурсы организма происходит не предсказуемый пока каскад нарушений
физиологических, биохимических и иммунных процессов с клинически очевидными
последствиями. Как оказывается, кишечные, кожные, кардиоваскулярные,
мочеполовые и другие заболевания причинно-следственно связаны с изменением
микрофлоры местной локализации и кишечной, как депо микроорганизмов в теле
человека. Данные молекулярных методов, в том числе и масс-спектрометрия
микробных маркеров, полученные в конце ХХ века, заставляют по-новому отнестись
к регулированию взаимоотношений хозяина с собственной микрофлорой. Концепция
моноэтиологичности заболеваний микробного происхождения, деление микробов на
патогенные и непатогенные должны быть пересмотрены. Все микробы, обитающие в
организме человека, одновременно пребывают в этих двух ипостасях. Любой из них
может быть причиной воспалительных процессов. Даже, казалось бы, святые
лактобациллы и бифидобактерии оказываются причиной, например, гнойничковых
поражений кожи промежности. Исключение составляют лишь агенты особо опасных
инфекций, возбудители чумы, холеры, сибирской язвы и других. Хотя есть и
«исключения из исключений» например, носительство возбудителей бруцеллеза или
туберкулеза. Самый парадоксальный случай
– возбудитель смертельно опасного заболевания – газовой гангрены – Clostridium perfringens является одним из самых
распространенных видов микроорганизмов толстого кишечника и фекалий.
Должна быть пересмотрена и концепция
антибиотикотерапии. Ее фундамент – микробная моноэтиологичность и резистентость
штаммов к антибиотикам в монокультуре in vitro – не адекватны форме существования
микробного сообщества человека в норме и патологии. То же самое относится и к
пробиотикотерапии которая в основном базируется на представлении о доминирующей
роли бифидобактерий в микробиоте кишечника. В результате из поля зрения
микробиолога, врача и биотехнолога выпадают эубактерии, клостридии и
актиномицеты, которых в кишечнике по современным оценкам на порядок больше, чем
бифидобактерий. Однако такие перемены в умах и традициях требуют времени.
Что можно извлечь сейчас из
результатов молекулярных исследований для пользы пациента? Пока лечение по
данным панорамного анализа микроэкологического статуса организма в целом (по
маркерам в крови) и в биологических жидкостях локусов в стадии освоения
несколькими врачами разных специальностей в Москве и некоторых городах России.
Стабильные результаты получены в гинекологии. Обнадеживает проступающая при
статистической обработке данных тенденция к нозологической специфичности
изменений микрофлоры кишечника и локуса.
Иначе говоря, для каждого заболевания характерны сходные у разных пациентов
изменения микрофлоры как в очаге воспаления, так и в кишечнике. Если это
подтвердится, то уже в скором времени стандартное лечение можно будет назначать
по клиническому диагнозу, если нет возможности провести подробное
микроэкологическое обследование. Но при этом потребуется освоить новую лечебную
квалификацию: специалиста по коррекции
дисбиозов.